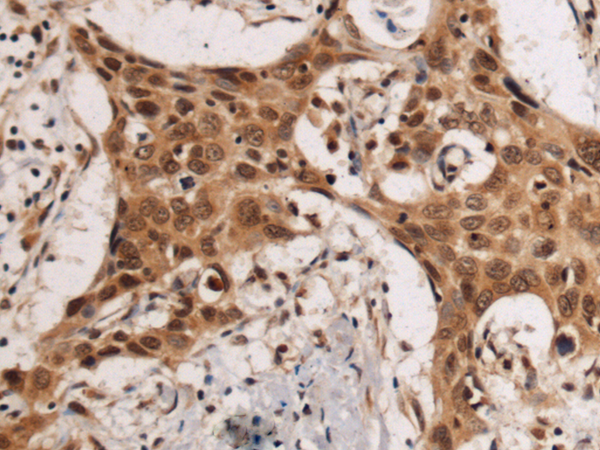

|
Background: |
Activator protein-2 alpha (AP-2 alpha) is a developmentally-regulated transcription factor and important regulator of gene expression during vertebrate development and carcinogenesis. The protein encoded by this gene is a member of the Kruppel-like zinc finger protein family and can repress expression of the AP-2 alpha gene by binding to a specific site in the AP-2 alpha gene promoter. Repression by the encoded protein requires binding with a corepressor, CtBP1. Two transcript variants encoding different isoforms have been found for this gene. [provided by RefSeq, Jul 2008] |
|
Applications: |
ELISA, IHC |
|
Name of antibody: |
KLF12 |
|
Immunogen: |
Fusion protein of human KLF12 |
|
Full name: |
Kruppel like factor 12 |
|
Synonyms: |
AP2REP; AP-2rep; HSPC122 |
|
SwissProt: |
Q9Y4X4 |
|
ELISA Recommended dilution: |
5000-10000 |
|
IHC positive control: |
Human esophagus cancer |
|
IHC Recommend dilution: |
50-200 |
購(gòu)物車
幫助
021-54845833/15800441009
